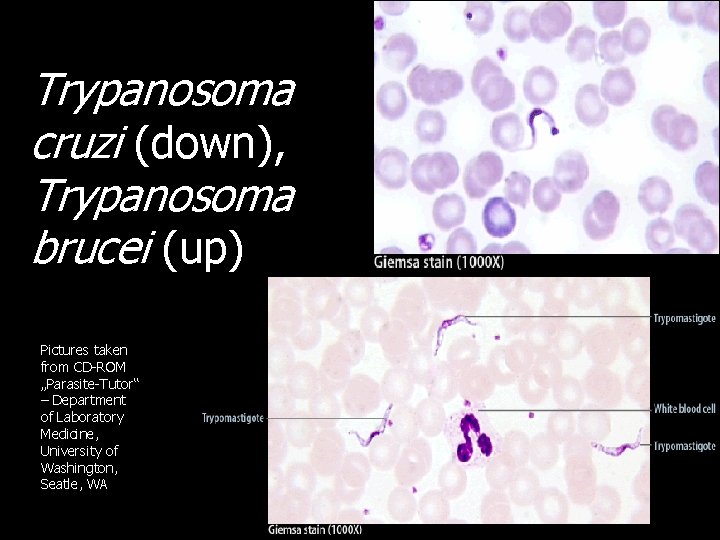
Trypanosoma cruzi (down), Trypanosoma brucei (up) Pictures taken from CD-ROM „Parasite-Tutor“ – Department of

Searching for microbes Part XIII Parasitology Ondej Zahradnek

Searching for microbes Part XIII. Parasitology Ondřej Zahradníček To practical of VLLM 0421 c zahradnicek@fnusa. cz

For introduction… Picture by: Petr Ondrovčík Are you sure, that your new clone of giant bed-bug is my favourite birthday present?

Survey of topics Parasites – introduction Parasites – clinical description Parasites – sampling Parasites – diagnostic methods Parasites – pictures Check-up questions

Parasites – introduction

Parasites classification • Parasites are clinically important animals, not allways microscopical. They may be classified according to placing inside the organism, zoological criteria and other properties. • Endoparasites (inner parasites): – Protozoa (amoebae, flagellates etc. ) – Roundworms (pinworm, common roundworm, Trichuris, dog and cat roundworm) – Flukes (liver fluke, schistosoma) – Tapeworms (swine tapeworm, beef tapeworm, fish tapeworm, dwarf tapeworm) • Ectoparasites are mostly various arthropods

Historical term „worms“ • The term „worms“, or its latin equivalent „helmints“ was historically used for organisms with prolonged shape of body • For practical reasons, we use this term sometimes even now, although we know already for a long time that they are not a taxonomic unit • Majority of them are visible by a naked eye or a simple lens. Some of them are quite large (e. g. 10 m in common tapeworm). Their eggs are microscopical

Flat worms and roundworms • Zoologically, there at least two unrelated groups of organisms • Flat worms (Plathelmintes) are really flat at section. Among clinically important organismes we have here – Flukes (Trematoda) and – Tapeworms (Cestoda) • Roundworms (Nemathelmintes) are round section. Group Nematoda belongs here

Another parasites classification • It is also common to classify endoparasites according to organ system where they are present: – – – Intestinal parasites (from Giardia to tapeworms) Blood parasites (intra- a extraerytrocytal) Urogenital parasites (e. g. Trichomonas) Tissue parasites (e. g. Toxoplasma) Other parasites (e. g. eye parasites) This classification is important also for diagnostics. Logically, in tissue parasites e. g. indirect diagnostics is more important: for direct diagnostics it is difficult to find a proper specimen to be taken

Parasites – clinical description

Story one • Little Nicol all the time scraped her buttocks, and it was evident to parents and teachers that something is wrong. She was also inquiet and unconcentrated. So they placed a translucent scotch-tape on her anus and sent to the laboratory. And the result did not surprise anybody. Nicol started to use drugs and in a short time everything was in order again…

Causative agent was www. medmicro. info Enterobius vermicularis or pinworm. It is a tiny roundworm (♂: 2– 5 mm, ♀: 8– 13 mm) that is present in the intestine. The eggs are present in perianal area. It is present mostly in children collectives. In small children autoinfections often occur. Another related roundworm is common rondworm – Ascaris lumbricoides. It is much longer (♀: 20– 35 cm, ♂: 15– 30 cm). It is a little simillar to earthworm (Lumbricus terestris), but still slightly different (roundworms have no band – citellum). Roundwors may cause various problems, from allergic problems to mechanical obliteration of orifices of bile bladder and

Pinworms http: //www. marksimonianmd. com/pin-worms/ http: //hpathy. com/cause-symptoms-treatment/worms-intestinal-worms-in-humans/

Pinworm: egg, worms, life cycle http: //www. earthty m. net/refpinworms. htm http: //www. tpub. com/conte nt/armymedical/MD 08420178. htm

Roundworms www. sp 01. com/micro/worms/imagepages/image 1. htm.

Roundworm versus Earthworm http: //stanford. edu/group/esw/wiki/Image: Adult_Worm. jpg http: //animals. howstuffworks. com/worms/earthworm-info. htm

Roundworm life cycle and world distribution http: //stanford. edu/group/esw/wiki

Intestinal parazites • Intestinal parazites are the most common ones. They may belong to any of endoparasital group. Some of them result in diarrhoeic diseases, some of them produce rather non-specific problems (dyspepsia, pruritus, tiredness…) • Most common ones: Protozoa: amoebae (Entamoeba histolytica), flagellates (Giardia intestinalis = Lamblia). Nematoda: Pinworm, common roundworm and others. Trematoda: e. g. Fasciolopsis buski. Cestoda: common (swine and beef) tapeworm and other tapeworms

Non-pathogenous protozoa in the bowel • Not allways presence of parazites, especially protozoa, is a reason for treantment. There are many species, that are considered to be rather non-pathogenous. • The most important non-pathogenous protozoa are: Entamoea dispar (very simillar to pathogenous E. histolytica!), Entamoeba coli, Entamoeba hartmanni, Endolimax nana, Iodamoeba buetschlii and others.

Story two • Bianca, who took care of several cats, had enlarged lymphonodes for some time, and long time it was a question, what is the reason. The throat swabs showed nothing, and also results ot other investigations were resultless. • Bianca planned to have a child, and so she was affraid. And it was shown, that it is really so: the causative agent responsible for her lymphonode sydrome is really sometimes dangerous for pregnant women…

The causative agent was • Toxoplasma gondii, a protozoon, that is transmitted by cats, although people say that people with dogs are in risk more than people with cats (they can wear the particles of cat faeces in their fur) • In immunocompetent persons, majority of infections is asymptomatical, or only with mild symptomas (enlarged lymphonodes). Rarely, ocular form may occur • In pregnant women toxoplasmosis may lead to abortion or embryonic organ defects • Even asymptomatic cases may lead to carriership of cysts, that is also asymptomatic. Toxoplasma may only reactivate in case of immunity problems (HIV+), especially in decrease of CD 4+ lymphocyte count

http: //web. indstate. edu Rare, but important: toxoplasma retinitis may occur… http: //fullmal. hgc. jp

Toxoplasma life cycle Down: toxoplasma cyst in brain www. antoranz. net webdb. dmsc. moph. go. th

Toxoplasma – how to get infected http: //www. dpd. cdc. gov/dpd x/html/Toxoplasmosis. htm

Toxoplasma – life cycle http: //en. wikipedia. org/wiki/File: Toxoplasmosis_life_cycle_en. svg

Tissue parasites • Some parazites may live inside the organism. – Some protozoa, like toxoplasma, produce parasital cysts. – Some nematodes may be present in tissue, e. g. Toxocara canis or T. cati – Some cestodes (e. g. swine tapeworm) may produce cysticercs in the tissue • Symptomatology is variable. In toxoplasmosis, cysts are clicinally quite mute. Cysticercs of tapeworms may be dangerous e. g. by pressing to important organs • Diagnostics is difficult, because it is usually nothig to take for direct diagnostics.

Tropical and subtropical tissue parasites • Among other important parasitoses there are leishmanioses. They occur in the whole tropical and subtropical band • Vector is a tiny blood sucking insect Phlebotomus • There exist some twenty important species, that may be classified into “Old world“ leishmaniae and „New world“ leishmaniae, and also to skin, skin-mucosal and visceral • They may cause diseases from skin mutilation to inner organ damage, often lethal

Leishmaniose http: //web. indstate. edu/thcme/micro/parasitolog y

http: //web. indstate. edu/th cme/micro/parasitology

Story three • Joddie had again gynecological problems. It was quite common in her, but this time bacteriological examination was of no help. So, C. A. T. swab was sent for examination, and so the result was found. Foto: Ondřej Zahradníček

Causative agent was • Trichomonas vaginalis, a flagellate, that is transmitted sexually, although exceptionally other ways of transmission are possible, too • Discharge of typical smell and colour is typical • In men, the disease is usually asymptomatical • As treatment for anaerobic infections (metronidazol) is effective for trichomonosis, too, the number of trichomonad disease decreases in recent times.

Trichomonad discharge depts. washington. edu holebi. info/gids. php

So called „strawberry cervix“ webmedia. unmc. edu

Urogenital parasites • Among sexually transmitted parasital diseases, trichomonosis is the only really important (if not discussing the pubic louse). • Usually its diagnostic is done together with bacteriology examination, as the ethiology is rarely clear at the first moment • In the urinary tract, most important parasites are some flukes (schistosomas), i. e. Trematodes. Diagnostic is partially microbiological, partially histological.

Story four • Mr. Hiker used to travel thoughout the world. After coming back from the last trip he started to have some probles, he caugth fever, then it finished, but during two days it started again. The GP sent him to infection department. They took his blood and made a smear to two slides, using two various methods. And really the causative agent was…

Causative agent was • Plasmodium vivax, one of four species of malaric plasmodia • Malaria is worldwide one of the most serious diseases. It causes ilness of many persons every day, including many coming from Europe. • The worst course is in „tropical malaria“ or „malignant tertiane“, caused by P. falciparum. Fever mostly does not decrease. • Milder are both „benign tercianas“, caused by P. vivax and P. ovale. Fever comes in 48 h interval here. • The quartan, caused by P. malariae, is rare. Fever comes in 72 interval here.

web. indstate. edu

Bloostream parasites • Among bloodstream parasites, of course, malarial plasmodia are the most important, but not the only ones. • A flagellate, Trypanosoma brucei lives in bloodsteam, causing sleeping disease. Trypanosoma cruzi lives there too, producing Chagas disease • Nematodes – filariae may live in bloodstream, too (in tropical countries) • Symptomatology: in all of them fever appeares, other symptomas are related to the agent

Elefantiasis www. sp 01. com/micro/worms/imagepages/image 1. htm.

Dracunculiasis www. sp 01. com/micro/worms/imagepages/image 1. htm.

Parasites – sampling

Sampling • For intestinal parasites rectal swab is not sufficient, a bit of stool is needed (see more ) • For Trichomonas either a slide for Giemsa staining is sent (alone or in pair with another one for Gram staining), or a C. A. T. swab • For Acantamoeba used contact lenses are sent in their own fluid, eventually corneal scraping might be performed • For tissue parasites serum is sent usually • In other pararasites we sample ccording to situation (urine, content of a cyst)

Sampling for intestinal parasites • To send stool for parasitological sampling (usually using Kato and Faust methods), we need sample of stool sized like a hazel nut. A vessel for sampling need not be sterile. Unlike virological examination the sample does not need low transport temperature • Specimen sized like a coconut (as sometimes some student say) is not recomended

Sampling for pinworms • For pinwoms, it is possible to send a stool specimen as for other intestinal parasites, but it is not optimal, because a better method exists • It is Graham method, where a tape is placed around anal orifice, then removed, placed on a slide and sent to the laboratory (and here examined microscopically • For technical reasons, the method is not very useful for adult persons, here classical stool specimen is sent usually

Sampling for blood parasites • For blood parasites, it is recommended to send a thick smear and a thin smear. Thick smear is just a drop mixed by a corner of another slide, thin smear is spread to the slide by special movement. Thick smear is not fixated. Pictures taken from CD-ROM „Parasite-Tutor“ – Department of Laboratory Medicine, University of Washington, Seatle, WA

Some more sampling methods Search for Used sampling procedure toxoplasmosis serum (for antibodies) trichomonosis C. A. T. swab, or smear urinary schistosomosis histological examination giardiasis duodenal juice (or stool) acanthamoebiasis used contact lens

C. A. T. swab for urethral and vaginal sampling for Candida (yeast) and Trichomonas Here the swab is broken to fit into the test tube Foto: Ondřej Zahradníček

Parasites – diagnostic methods

Parasites: diagnostic methods • Microscopy is important, either wet mount, or staining (trichrom, Giemsa stain, Ziehl Neelsen for intestinal coccidia) • Culture is rarelly used, in practice only in Trichomonas and Acantamoeba. • Among other direct methods PCR is used recently • Indirect detection is used in tissue parasitoses, mostly toxoplasmosis, larval toxocarosis etc.

Intestinal parasites diagnostics • As a basis, we use methods based on modified wet mount: – In Kato method counterstain with malachite green is used, to make parasites better visible – Faust method is a concentration one (see later) • Graham method is used in pinworms only (see later) • Wet mount „sensu stricto“ and stainded preparations (e. g. trichrom) are used in increased suspicion for intestinal protozoa (either primarilly, or after seeing Faust and Kato)

Faust method In the second halft, Kato is already prepared • Principle: stool is repeatedly mixed with Zn. SO 4 solution, centrifugated and supernatant taken for the next step. Finally, the solution is filled up to the top of the test-tube and covered by a coverslip. The parasites adhere to the coverslip from below. Then coverslip is removed onto the slide with allready prepared Kato method.

Methods for diagnostics of intestinal protozoa • Helmint eggs are found directly in Faust and Kato methods. When something resembling cysts (of trophozoites) of protozoa is found, more methods are used. We use here – Wet mount, just stool mixed with a drop of saline, eventually a drop of Lugol solution is added after first observation to see better some structures – Trichrom staining. Fixation using alcohol-sublimate and further 70% alkohol, proper trichrom, 96% alcohol and carbolxylene. Or haematoxylin stain. – for cryptosporidia eventually Ziehl Neelsen, or , in Czechia, Miláček staining (Mr. Miláček was a laboratory, assistant in parasitology in České Budějovice)

Graham method in pinworm diagnostics • The patient bends forward, stretches his/her buttocks, and now a special transparent scotchtape is sticked on his/her anus and mostly perianal rugae. Then the tape is removed again and sticked to a slide. • Transparency of the tape is crucial, otherwise it is not possible to microscopy. (Nevertheless, some „experts“ send a non-translucent tape, or cover all the tape by a label with patient name) • It is easier and more effective than stool examination. It is still used rather in children – adults use to have to hairy anus, so the method woudl be too painflul and difficult.

Practical microscopy in Faust, Kato and Graham methods n n n In all three methods we use no immersion, objectives 10×, 20×, 40×. Faust and Kato methods are usually observed together, on the same slide Graham method result is microscopied just in the form how it comes to the laboratory, no preparation is needed.

Morphology of eggs of intestinal parasites You should know at least these shapes to the examination Pinworm Enterobius Trichuris Roundworm Ascaris Tapeworm Taenia Pictures taken from CD-ROM „Parasite. Tutor“ – Department of Laboratory Medicine, University of Washington, Seatle, WA. Tapeworm picture origin: http: //www. biolib. cz/cz/taxonimage/id 17433/? ta xonid=43809

Evaluation of protozoan diagnostics • Gomori trichrom or Heidenheim haematoxylin is used. Size of the protozoon, number of nuclei, in Entamoeba genus also central and peripherial chromatine • Unlike Entamoeba coli, E. histolytica has maximally four nuclei. Usually you cannot see all nuclei together, they appear and disappear during focusing. • Entamoeba histolytica/dispar cannot be differentiated microscopically, in reference laboratory PCR discrimination is performed

Diagnostics of blood parasites: thin smear and thick drop • In diagnostics of blood parasites it is important to perform a smear using special methods of thin smear and thick drop. • For both methods, fresh blood is used, of nonclotted blood, if the smear is not performed immediatelly. The thin smear is fixated, the thick drop is not. Both of them are Giemsa stained. • Look at following pictures.

Pictures taken from CD-ROM „Parasite-Tutor“ – Department of Laboratory Medicine, University of Washington, Seatle, WA Thin smear Thick drop

Microscopy of blood parasites – an example of a result • We use immersion system, 100× objective. The preparation is usually Giemsa stained. On the picture below, we can see erythrocytes and young trophozoites of Plasmodium falciparum. a platelet RBCells malarial trophozoites (ring form) a WBC

Erythrocytal stages of parasite, observable in the smears web. indstate. edu (Reduced to human erythocytal stages only, i. e. not liver stages and not mosquito stages) Merozoites

Pictures from CDROM „Parasite. Tutor“ – Department of Laboratory Medicine, University of Washington, Seatle, WA merozoites „ring-form“ gametocyte schizont older trophozoite mosquito Erythrocytar stages of plasmodia

Trichomonas diagnostics • Trichomonads are recently diagnosed mostly using culture-microscopical: – A C. A. T. swab is performed – The medium is cultured overnight – A drop of medium is microscopied as a wet mount. • The preparations cannot be preserved • Therefore in our practical we have the second possible way of diagnostics – Giemsa stained smear on a slide. When it is a part of „Microscopical appearance of vaginal microflora“ (MAVM), it is described as MAVM V. • Other ways (e. g. fluorescence staining, see picture) are used rarelly

Trichomonas – fluorescence http: //www. ncl. ac. uk/microbial_eukaryotes/christophej_no_euml_l. html

Microscopical preparations of Trichomonas in MAVM (Giemsa) • We use immersion microscopy (objective 100×, immersion oil) • In some preparations we can see yeasts, too • The pictures on Internet are usually ideal cases, oftend specially stained of computer adapted. http: //medschool. sums. ac. ir Trichomonas Leucocytes

http: //medschool. sums. ac. ir

Diagnostics of other parasital diseases • In ectoparasites majority of diagnostics is non -microbiological (everything can be observed by a laik, eventually a dermatologist in case of Sacroptes scabiei) • In tissue parasites serum for indirect diagnostics is sent usually (CFT, ELISA) • In some cases, mostly tropical parasitioses, it is better to consult sampling technique with a laboratory In some filarioses the sampling is recomended to perform during night only, or during day only.

Recognizing ectoparasites Bed bug Louse Itch mite Flea Crab louse Tick Cimex Pediculus Sarcoples Pulex Phthirus Ixodes

Diagnostics of Toxoplasma gondii using serological tests • In toxoplaxmosis, we often combine two tests. • Complement fixing test (CFT). It is performed like other complement fixing tests, see J 08 practical • ELISA, too, is like other ELISA reactions. One specific feature is that instead of Ig. M + Ig. G we mostly search for Ig. A + Ig. G antibodies. Ig. A antibodies are typical for recent infections, Ig. G for „status after“ an infection. Paradoxically, pregnant women with Ig. G + are in a better situation than Ig. G – (they are protected).

Parasites – pictures

Trichomonas vaginalis Pictures taken from CD-ROM „Parasite-Tutor“ – Department of Laboratory Medicine, University of Washington, Seatle, WA Wet mount Giemsa

Trichomonas vaginalis Wet mount Photo Ondřej Zahradníček

Giardia intestinalis (Lamblia) (trophozoites) Picture taken from CD-ROM „Parasite-Tutor“ – Department of Laboratory Medicine, University of Washington, Seatle, WA

Giardia intestinalis – trophozoites http: //www. smittskyddsinstitutet. se/presstjanst/pressbilder/parasiter/
Trypanosoma cruzi (down), Trypanosoma brucei (up) Pictures taken from CD-ROM „Parasite-Tutor“ – Department of Laboratory Medicine, University of Washington, Seatle, WA

Triatoma sp. , vector of Chagas disease http: //web. indstate. edu/thcme/micro/parasitology

Tse-tse fly (Glossina), vector of sleeping disease http: //web. indstate. edu/thcme/micro/parasitology

Leishmania sp. Picture taken from CD-ROM „Parasite-Tutor“ – Department of Laboratory Medicine, University of Washington, Seatle, WA

Entamoeba histolytica, haematoxylin www. medmicro. info

Acantamoeba sp. www. medmicro. info

http: //webdb. dmsc. moph. go. t h/ifc_nih/applications/pics/To xoplasma. jpg Toxoplasma gondii http: //www. smittskyddsinstitutet. se/upload/A nalyser/Toxoplasma. SB. jpg

Anopheles sp. , vector of malaria Picture taken from CDROM „Parasite-Tutor“ – Department of Laboratory Medicine, University of Washington, Seatle, WA

Taenia saginata http: //www. infovek. sk/predmety/biologia/ metodicke/ploskavce/index. php

Tapeworm eggs Attention, eggs do not enable discriminate between T. solium and T. saginata, we would need proglotids for this! http: //www. biolib. cz/cz/taxonimage/id 17433/? taxonid=43809 – foto mgr. Vladimír Bádr

Proglotid of a beef tapeworm (a swine tapeworm would have less branches) Pictures taken from CD-ROM „Parasite -Tutor“ – Department of Laboratory Medicine, University of Washington, Seatle, WA

Pinworm with eggs Pictures: Milada Dvořáčková a Ondřej Zahradníček

Comon roundworm eggs Pictures taken from CD-ROM „Parasite-Tutor“ – Department of Laboratory Medicine, University of Washington, Seatle, WA (left) amd www. medmicro. info (right)

Trichuris trichiura Picture taken from CD-ROM „Parasite-Tutor“ – Department of Laboratory Medicine, University of Washington, Seatle, WA

http: //plpnemweb. ucdavis. edu/N emaplex/Taxadata/Tcanis. htm

Toxocara canis http: //www. vet-doktor. de/ARCHIV/Gesundheit/Wurmprophylaxe/wurmprophylaxe. html

Trichinella spiralis http: //www. medchem. com/Para/prob%20 of%20 month/Pro b%20 of%20 Month%2012%20 December. ht m

Filariae A – Wuchereria bancrofti B – Brugia malayi C – Loa loa D – Mansonella perstans E – Mansonella ozardi Pictures taken from CD-ROM „Parasite-Tutor“ – Department of Laboratory Medicine, University of Washington, Seatle, WA

Sarcoptes scabiei http: //www. kcom. edu/faculty/chamberlain/We bsite/lectures/lecture/jens. htm

Pubic louse http: //www. ento. okstate. edu/ddd/insects/pubiclice. ht m

Head louse with an egg www. museum. vic. gov. au/bugs/image. aspx? ID=96. www. stanford. edu/class/hu mbio 103/Para. Sites 2002/pedi culosis/biology. html www. pbase. com/image/34663240.

http: //tn 3 -2. deviantart. com/300 W/fs 7. deviantart. com/i/2005/189/1/9/toxoplasma_by_chocko. jpg The End Picture on this page – toxoplasmosis in artistic view

Check-up questions • 1. What diseases are caused by protozoa of genus Leishmania? • 2. What are bloodstream parasites other than malaric plasmodia? • 3. What are staining methods for diagnostics of Giardia and intestinal amoebae? • 4. What staining method can be used for diagnostics of Cyclospora cayetanensis and Cryptosporidium parvum? • 5. Which non-pathogenic intestinal amoeba cannot be distinguished microscopically from Entemoeba histolytica? • 6. What are diseases transmitted by Glossina fly, Anopheles mosquito, Aëdes mosquito, Ixodes ricinus tick, Phlebotomus gnat • 7. What is the name of the artificial (iatrogenous) myiase used for treatment? (It is a method, where larva of Lucillia serricata fly are administered to the wound to eat diseased, but not healthy tissue. )
- Slides: 95